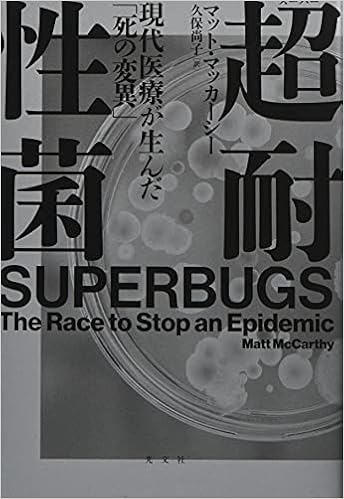
超耐性菌 現代医療が生んだ 死の変異 マット マッカーシー 久保 尚子 本 通販 Amazon

√100以上 イカ 耐性 310693-イカ 僧侶 耐性
メイヴ5に武闘家で勝った人の装備アクセはこれだ! ダークキング5にバトで勝った人の装備アクセはこれだ! トライバル編 第7弾は メイヴ(イカ)5に僧侶で勝った人の装備 です。 青さまのお友達の ジークハルトさん です。 構成は武闘家2、道具水系 2395 17 5HP MP 攻撃力 守備力 結晶Lv 制限なし 耐性・弱点フォース 炎 氷 風 雷 土 闇 光;試練の門 邪神 強ボス ピラミッド マヒ

ドラクエ10 新コインボスムドーの必要耐性やアクセ効果について Game小鳥ちゃん
イカ 僧侶 耐性
イカ 僧侶 耐性- 呪文耐性も60%あるとマジバリ2段階でノーダメージになるしマジバリなくても条件次第でまあまあ耐えます。 2)宝珠 うたれ名人ややいばのぼうぎょの宝珠はmax、会心完全ガードも入れましょう。あとは回復魔力などにより調整ですが、注意するのは ①回復魔力を1以上は無駄に盛雷耐性100%の僧侶はほとんどいなかったので、無理に雷耐性を積む必要はない感じがします。 その他の職について こちらの記事もどうぞ♪ ドラクエ10Ver35後期 常闇の聖戦海冥主メイヴ(イカ)『戦士』100人の装備を調べてみた




Dqウォーク だいおうイカのこころは バギ属性ダメージと耐久力が上昇する持久戦用 電撃dqw日記 3 電撃オンライン
ほかの耐性については普段必要と感じるものを選ぶのが良いと思います。 天地雷鳴士の耐性が必要になるもの 初心者さんがよく行くコンテンツの耐性について簡単にまとめてみました。 だけど これがこのまま必要な耐性にはならない ので注意です!メイヴⅤに挑む為の装備 Sera blog↑こち雷耐性をつけておくと楽になるので、ストームタルトや風雷のいんろうを用意しましょう! ギガデイン 雷100%のイカ用耐性装備を考えてみました! 関連記事 最近サポでメイヴ討伐周回をやっています! どうもメイヴラグナです。 最近サポで海冥主メイヴ討伐周回をやってるので、その方法約950ダメージ+全属性耐性低下+HP大ダウンの呪い+混乱+特技封印+移動速度低下+幻惑 ※海冥主メイヴLv1は、すべての属性ダメージを09倍に軽減 ゲノムデビル 黄なる海冥の浸食約12秒後に9999ダメージ×2回;
大王イカのステータス 系統 経験値 ゴールド 特訓 格下Lv; ドラゴンクエストXランキング ひょんないきさつからノー勉強で、はじめてイカ5(メイヴ5)とふれあった私は、イカ5料理にチャレンジするが如ゴトく、急にレシピをあさり猛勉強を始めました。 naana10hatenadiaryjp え?Amazon Primeの設定と見方がわからない! イカサ 固有アビリティ(秘匿騎士) ・『死閃』のhp低下時の威力・使用回数を上方修正 ・『裏三途』の威力・使用回数を上方修正&斬撃耐性ダウンを2回まで重複可に変更 ・『死忘華』の回復無効効果を自身の状態異常耐性に関わらず発動するように変更
拝啓 先生 なんか今日の東京は冬なのにちょっと暖かいけど、いかがお過ごしでしょうか。 昨日、先生がイカ耐性で酒場にいらっしゃったので、ボクは 火耐性大 とれとれふんばり どきどき 気まぐれ コダイオウイカの リング揚げ ロックラッカセイ + コダイオウイカ 体力50 スタミナ0 水耐性大 とれとれふんばり どきどき 気まぐれ 雪山ベルナスの 朴葉焼き ユキヤマツタケ + ベルナス アロンアルファは水に弱いらしいのでエポキシ接着剤を買う FLビシの上窓調整の硬さを調整する のに割れていたリングをアロンアルファで接着したら、 深場の勇者様 & 賢者様 からダブルでダメだしをくらう。 アロンアルファは耐水性に問題があり水中




しいか 耐性 Snowmanで妄想



パズドラです 毒耐性4個で80 毒耐性バッチで50じゃないですかこれ Yahoo 知恵袋
09 1 1 12 1 1 09 天地雷鳴士の耐性が必要になるもの 初心者さんがよく行くコンテンツの耐性について簡単にまとめてみました。 だけど これがこのまま必要な耐性にはならない ので注意です! 耐性装備がないと苦戦を強いられることになりますので、ぜひ耐性装備を整える際の参考にしてみてください。 属性耐性100%装備はこちら 年5月6日 ドラクエ10属性耐性100%装備の組み合わせを初心者向けに完全網羅!




ロマサガrs Ss ライザ 相手を間違えたわね スタイル評価 考察 多段攻撃の最大ヒットも超える 超火力打アタッカー登場 ページ 2 ロマサガrs攻略まとめ 開発ブログ




強敵ゆきのじょおうの攻略法 弱点 耐性 こころsの能力はこちら
雷耐性は始原の雷撃を喰らった時用 で、 始原の雷撃は十分避けれる上に即死技ではありませんが喰らうとhpが聖女ライン(hp50%)を割ってしまう ので、聖女ラインを割らないように調整する用になります。hpが聖女ラインを割っていると、その後回復が追い付いていない間に追撃された周囲に950程度のダメージ+全属性耐性低下+封印+呪い+混乱 ギガデイン 必ず暴走し、対象と周囲に3500程度のダメージ(表示は2999) 守護石 守護石を壊すとテンション2段階アップ 守護石を壊す2秒間加護がエリア全体化する。 Ⅲとの違い hp、攻撃力、守備力、各種耐性が上昇 感電ドラクエ10 イカ耐性, 海冥主メイヴⅣ攻略構成 必要耐性 ドラクエ10攻略 検証ブログ Home 攻略・検証 海冥主メイヴⅣ攻略構成 必要耐性 海冥主メイヴⅣ攻略構成 必要耐性 ・イカ召喚ギミックに変化なし 最後までイカは相変わらず1匹、守護石は2個で普遍でした。 ・「回転アタック」を 月は10%




ドラクエウォーク だいおうイカはバギデイン弱点で戦いやすい 幻惑に注意 大王いか




Dqウォーク だいおうイカのこころは バギ属性ダメージと耐久力が上昇する持久戦用 電撃dqw日記 3 電撃オンライン
幻惑耐性のこころ一覧 だいおうイカのこころの弱い点 ちからが低い ちからが48と低い点がネック。そのためだいおうイカのこころ1つで、バギ属性威力を大きく向上させられるというほどではない。 何個sを入手するべき? 2個を目指そう だいおうイカはバギ属性スキルを使う場面や、幻雷耐性10 マスターイカフライバーガー コダイオウイカ マスターベーグル 50 25 防御15 氷耐性3 大 防御 氷耐性10 ベルナスの吟醸酒粕漬け 酒 ベルナス 大吟醸・龍ころし 50 25 防御15 龍耐性3 大 防御 龍耐性10 系統 料理名 食材 ハンター オトモ 体力 スタミナ テンション幻惑(前衛職業は必須) メイヴは非常に厄介な状態異常を多く付与させてきます。 その中でも、特に上記の2つは必須ですね。 その他にあれば安心できる耐性として 呪い;




ドラクエ10 新コインボスムドーの必要耐性やアクセ効果について Game小鳥ちゃん



何に見える あなたの ストレス耐性の高さ がわかる心理テスト Trill トリル




ドラゴンクエストウォーク メガモン だいおうイカの攻略 Sのこころ詳細を紹介 スマホゲーム情報ならファミ通app




心理テスト 実はほっとくとヤバいかも あなたの 寂しさ耐性 を測定します 21年4月23日 エキサイトニュース




14 号 酵素耐性デンプンおよびその製造方法 Astamuse




遷悠種の属性やられと対策 Mhf Z 狩人のミタ




Dksw Xvufo7kzm




炎の宝珠鉄壁のブレス耐性をダースギズモからとってきましたよ ドラクエ10ブログくうちゃ冒険譚




鶏肉における薬剤耐性サルモネラ 一般財団法人 東京顕微鏡院




だいおうイカの攻略 弱点と対策 ドラクエウォーク ゲームウィズ




調査 結局イカ4の必要耐性ってどれなんだろう




だいおうイカの弱点と耐性 注意点速報 まもりの だいおうイカの話題 21 2 12 金 17時頃 ツイ速クオリティ Twitter




だいおうイカの弱点と耐性 注意点速報 まもりの だいおうイカの話題 21 2 12 金 17時頃 ツイ速クオリティ Twitter




Amazon Co Jp スプラトゥーンホワイトインクリングイカ コーヒーカップ マグ おしゃれ マグカップ 人気 水筒 創意 シェラカップ 高温 耐性 カップ ミルクカップ ドリンクカップ ジュースカップ 陶器製 大容量 330ml ホーム キッチン



海冥主メイヴ 攻略構成 必要耐性 ドラクエ10攻略ブログflooded With Business




ドラクエウォーク だいおうイカの攻略 弱点倍率と倒し方 メガモンスター




みんドラ ドラクエウォーク攻略 だいおうイカの弱点と耐性 注意点速報 まもりのたては必須 マヒャドが痛いのでヒャド耐性はしっかり ゲッソー 我の怒りを受けてみよ の次のターンで3回攻撃が来ます T Co Hutdwx67ew Dqウォーク




大ヒット診断の第二弾 最強のぼっち耐性度診断 Mirrorz ミラーズ 無料の心理テスト 診断 占い




ドラクエウォーク だいおうイカ攻略 弱点 耐性 メガモンスター ゆきしばブログ




Dqウォーク だいおうイカの弱点と耐性をまとめてみた ドラゴンクエストウォークまとめ速報




抗菌薬が効かない 薬剤耐性 Amr が拡大 一人ひとりができることは 暮らしに役立つ情報 政府広報オンライン




Amazon スペースオレンジイカオーブンミットと鍋つかみキッチン 料理 ベーキング グリル用のポリエステル滑り止めバーベキューグローブ付き4耐性ホットパッドのセット 鍋つかみ ミトン オンライン通販




チャンピオンオールスターズ パズドラ コラボ 全キャラ性能解説 もみぐり Note




夜更のアサカゼ アナデン パーソナリティ いぬ好き Accretion Disk Insura Ventorum 自分のバフデバフリセット 物理耐性70 Up 全属性耐性70 Up Amorphous Lacus Solitudinis Hp約1000万回復 物理耐性70 Up 全属性耐性70 Up 耐性バフの性能がイカ




ドラクエウォーク ヒャド属性耐性のこころ 装備一覧 Dqウォーク ゲームウィズ



Lh3 Googleusercontent Com Proxy V8bpxda4ds Twjkjypbysaut0m5u4yzvp6clk Hfx3rwjm4uiyp8nwtncawkmjf8gcw Swmn2iye9d4kclhcbfs7mlrd7xyirrosima Ozfd6vkrbowhljhfyixdcfzg1jne Xkfafsuc8go6cmiaah G5je9tlml4uqlcgq61juf6ph1hh3d6kzpyrba




雷100 のイカ用耐性装備を考えてみました ドラクエ10攻略 ラグナのブログ




ドラクエウォーク だいおういか攻略 弱点 耐性 回復 使ったほうがいいのでは Youtube




超耐性菌 マッカーシー マット 著 mccarthy matt 久保 尚子 訳 紀伊國屋書店ウェブストア オンライン書店 本 雑誌の通販 電子書籍ストア




Twitter Comics Manga Character



パズドラ 雲耐性 持ちモンスターの一覧と効果 パズドラ攻略 神ゲー攻略




特集 カルバペネム耐性腸内細菌科細菌 Cre 日本bd




パズドラ 雲耐性持ちモンスターの一覧 ゲームウィズ




塩味耐性 低下か 外食のしょっぱさに拒絶反応 立花聡公式サイト




Dqウォーク 心珠の耐性系ってもう合成しちゃっていいかなぁ ドラゴンクエストウォークまとめ速報




だいおうイカの弱点と耐性 注意点速報 まもりの だいおうイカの話題 21 2 12 金 17時頃 ツイ速クオリティ Twitter




惨敗 光耐性100魔剣士で挑んだキラークリムゾンサポ討伐 ドラクエ10ブログ ウェイル ミーティアのアストルティアリサーチ




雷100 のイカ用耐性装備を考えてみました ドラクエ10攻略 ラグナのブログ




だいおうイカの弱点と耐性 注意点速報 まもりの だいおうイカの話題 21 2 12 金 17時頃 ツイ速クオリティ Twitter




ドラクエウォーク だいおうイカの攻略と弱点 対策は メガモンスター ゲームエイト

超耐性菌 現代医療が生んだ 死の変異 マット マッカーシー 久保 尚子 本 通販 Amazon




ドラクエウォーク だいおういか攻略 弱点 耐性 回復 使ったほうがいいのでは Youtube




テリワンsp 大王イカの配合表と入手方法 テリーのワンダーランドsp アルテマ



海冥主メイヴ 攻略構成 必要耐性 ドラクエ10攻略ブログflooded With Business




ドラクエ10 ムドーの倒し方 サポ構成攻略と必要耐性について これで私は無敗ですw Dq10 まさとるてぃあ




パズドラ 雲耐性の効果と所持モンスター一覧 Appmedia




調査 結局イカ4の必要耐性ってどれなんだろう




ドラクエウォーク だいおういか攻略 弱点 耐性 回復 使ったほうがいいのでは Youtube




イカのレベル2を倒してきました メイヴ ドラクエ10攻略 ラグナのブログ




勇者姫アンルシアの 耐性しょうさい うさぎ紳士のドラクエ10日記




テイクレ超絶戦ガイアス 敵の行動や耐性などまとめ レベル1 8 ちゃこっとな




だいおうイカの弱点と耐性 注意点速報 まもりの だいおうイカの話題 21 2 12 金 17時頃 ツイ速クオリティ Twitter




Dqx耐性チェッカー ドラクエ10 アストルティア最強剣士を目指すブログ ドラクエ10




鶏肉における薬剤耐性サルモネラ 一般財団法人 東京顕微鏡院




海賊初陣 メガモンスターだいおうイカをソロ討伐 ドラクエウォーク無課金の歩き方




新型コロナウイルスだけじゃない感染症の逆襲 医療 社会保障 記事 論考 調査研究 読売新聞オンライン




汎用性の高い耐性装備をそろえよう ドラクエ10 アストルティア最強剣士を目指すブログ ドラクエ10




10個の質問に答えて探る あなたの 恋愛ストレス耐性 はどれくらい モデルプレス




ドラクエウォーク だいおうイカの攻略 弱点倍率と倒し方 メガモンスター




Amazon Co Jp パーティー用の明るい色のフェード耐性レトロクラーケンイカガーデンフラッグ装飾 ホワイト 12 5 X18 Diy 工具 ガーデン



レグナード




ドラクエウォーク だいおうイカ攻略 弱点 耐性 メガモンスター ゆきしばブログ




Dqウォーク 新メガモン だいおうイカは全体攻撃多め Hp管理を大切に 電撃dqw日記 816 電撃オンライン




ドラクエ10 常闇の聖戦を攻略しよう メイヴ僧侶編 Gameholic



どのように耐性化するのか 薬剤耐性菌について 一般の方へ かしこく治して 明日につなぐ 抗菌薬を上手に使ってamr対策




原神 翠緑セットの耐性ダウンってひょっとして強そうに見えて微妙 原神攻略まとめ テイワット速報




ドラクエウォーク 攻撃減耐性のこころ 装備一覧 Dqウォーク ゲームウィズ




メイヴ4 ムチまもサポ キメラとイカ4倒してみた ドラクエ10ブログ エル子のバトル日記




雷100 のイカ用耐性装備を考えてみました ドラクエ10攻略 ラグナのブログ




ドラクエウォーク だいおうイカの攻略方法と弱点 出現時間まとめ メガモンスター 攻略大百科




アビスセーラーで雷耐性100 にしてみたよ まんまる堂 ドラクエ10




テリワンレトロ とさかへびの配合方法 特技 ステータス 耐性データ じっぺゲーム テリワンレトロ攻略




心層の迷宮 悔恨の園30階攻略には呪文耐性が便利 ドラクエ10ブログ エル子のバトル日記




ドラクエウォーク だいおうイカ攻略 弱点 耐性 メガモンスター ゆきしばブログ




心理テスト 実はほっとくとヤバいかも あなたの 寂しさ耐性 を測定します 笑うメディア クレイジー




雷100 のイカ用耐性装備を考えてみました ドラクエ10攻略 ラグナのブログ




ムドーの必要耐性と行動を調べてきました ドラクエ10ブログくうちゃ冒険譚




時空英雄伝説リターンズ 無属性攻撃耐性 Roの日常 3日目




メイヴ5 僧侶に幻惑 装備や立ち回りを勉強しました おやすみ 彡メギストリス




ドラゴンクエストウォーク メガモン だいおうイカの攻略 Sのこころ詳細を紹介 スマホゲーム情報ならファミ通app




だいおうイカの弱点と耐性 注意点速報 まもりの だいおうイカの話題 21 2 12 金 17時頃 ツイ速クオリティ Twitter




ストレス耐性とは 高い 低い人の特徴 鍛え方 チェックする方法 カオナビ人事用語集




ストレス耐性とは Compass適性検査bygdl




公益財団法人 河川財団 河川基金 河川基金からのお知らせ トンボの生態から薬剤耐性菌を探る ジュニア研究者の奮戦




ドラクエウォーク だいおうイカ攻略 弱点 耐性 メガモンスター ゆきしばブログ




家畜の飼い方は変えなくてよいのか 薬剤耐性菌問題の今 Peace 命の搾取ではなく尊厳を




わんこの恐竜図鑑 11 カルボネミス 猫な犬の日常



どのように耐性化するのか 薬剤耐性菌について 一般の方へ かしこく治して 明日につなぐ 抗菌薬を上手に使ってamr対策




いかずちのつえでイオマータ ドラクエ2イベント第3章 15時から ドラクエウォークゆる攻略ブログ ひろさんぽ




ストレス耐性が低い部下にどう対処する 注意の仕方と育成方法




しいか 耐性 Snowmanで妄想




抗菌薬が効かない 薬剤耐性 Amr が拡大 一人ひとりができることは 暮らしに役立つ情報 政府広報オンライン




麻痺耐性をアップするこころと装備 ドラクエウォーク




酒場の耐性検索がすごい 属性100 が簡単に見つかる てぃも忘備録




だいおうイカの弱点と耐性 注意点速報 まもりの だいおうイカの話題 21 2 12 金 17時頃 ツイ速クオリティ Twitter
コメント
コメントを投稿